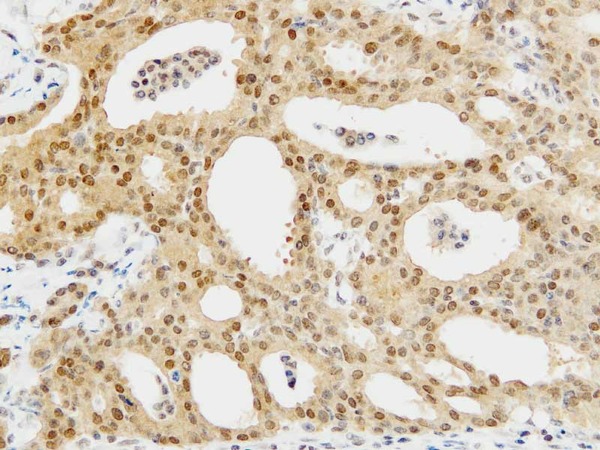

#28135 Anti- OPRT Rabbit IgG Affinity Purify
- 使用用途:
- 研究用試薬
- アプリケーション:
- WB, IHC
- 容量1:
- 100 μg
- 価格1:
- 64,000円
- 容量2:
- 10 μg
- 価格2:
- 17,000円
- アプリケーション略称の説明
- WB:ウェスタン・ブロッティング
- IHC:免疫組織化学
※ 診断や医療目的に用いることはできません。
※ 掲載のデータシートは見本です。ご使用の際には物品同梱のデータシートをご確認ください。
※ 海外からの取り寄せ品 (主に#82xxx) は事前通知なく販売中止または、最低注文数量が設定されることがあります。
製品概要
製品概要
| 製品コード | 28135 |
|---|---|
| 製品名 | Anti- OPRT Rabbit IgG Affinity Purify |
| メーカー名 | 株式会社免疫生物研究所 |
| 使用用途: | 研究用試薬 |
| アプリケーション | WB, IHC |
| 免疫抗原 | Human OPRTの部分合成ペプチド (ISAADRLEAAEMYRKAAWEAY: 454-474) |
| 精製方法 | 抗原ペプチドによる特異精製 |
| 包装形態 | 1 % BSA, 0.05 % NaN3含有PBS 1.0 mLに溶解したものを凍結乾燥 |
| 保管 | 2~8℃ |
| 毒物劇物 | 該当 |
| カルタヘナ | 非該当 |
| 容量1 | 100 μg |
| 価格1 | 64,000円 |
| 容量2 | 10 μg |
| 価格2 | 17,000円 |
| 備考1 | 商業製品の原料としてお求めの場合、当社の許可が必要となります。 |
製品説明
製品説明
生体の核酸代謝に関連するkey enzymeとして、チミジル酸合成酵素(Thymidylate synthase/TS : EC 2.1.1.45)、ジヒドロピリミジン脱水素酵素(Dihydropyrimidine degydrogenase/DPD ; EC 1.3.1.2)、リン酸化酵素であるチミジンフォスフォリラーゼ(Thymidene phosphorylase/TP : EC 2.4.2.4)及びオロチン酸ホスホリボシル転移酵素(Orate phosphorybosyl transferase/OPRT : EC 2.4.2.10)が知られています。 消化器がん、乳癌などの固形がんに対して汎用されている抗がん剤に、代謝拮抗剤の5FUがありますが、これらの酵素は5FUの活性化、代謝、分解に関連する酵素としても知られており、5FU系抗がん剤の効果との関連性が報告されています。さらにTS、DPD等はがん患者の予後に関連する因子としても報告されています。 このように本抗体は、核酸研究や5FU系抗がん剤の効果予測、予後予測因子探索を始めとするがん組織でのタンパク発現の検索に有用です。